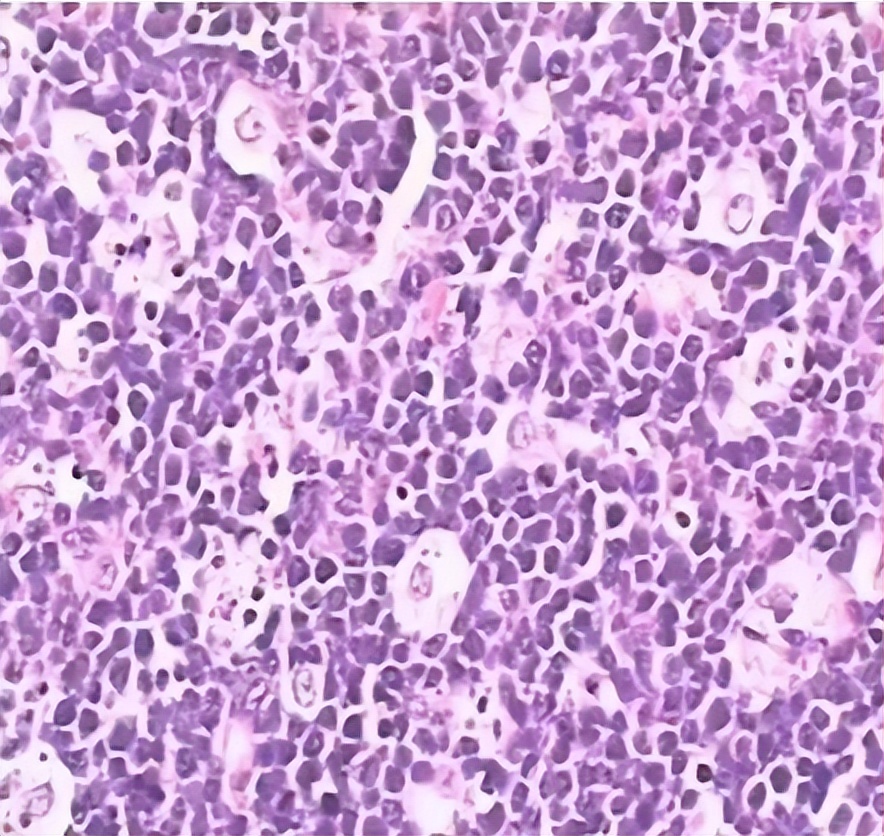

赵东陆教授:伯基特淋巴瘤指南要点解读丨2024年金陵淋巴肿瘤论坛
编者按:2024年5月11~12日,“2024年金陵淋巴肿瘤论坛” 在南京隆重召开,该会议主要采取线下交流的方式,邀请了国内外淋巴肿瘤领域的著名专家授课,并通过病例讨论等其他多种形式,围绕国际淋巴肿瘤基础及临床领域最新成果和进展进行交流,旨在进一步提高我国淋巴瘤的整体诊疗水平。在该会议上,哈尔滨血液肿瘤研究所赵东陆教授围绕“CSCO淋巴瘤诊疗指南—伯基特淋巴瘤指南要点解读”的课题进行了详细介绍,为了深入了解该方面的内容,《肿瘤瞭望-血液时讯》特整理了其内容,供读者参考。

伯基特淋巴瘤(BL)概述
疾病特征
伯基特淋巴瘤(Burkitt Lymphoma, BL)是一组起源于滤泡中心B细胞的高度侵袭性淋巴瘤亚型,约占成人非霍奇金淋巴瘤(NHL)的2%,儿童及青少年NHL的40%左右,其恶性程度极高,细胞倍增周期很短,生长迅速,若不及时治疗,患者可在数个月内死亡。BL的病变可累及全身各组织器官,常发生于结外部位或表现为急性白血病,其中骨髓和中枢神经系统(CNS)是BL最常累及的部位。
BL的诊断
BL确诊需依赖活检病理、临床特点、细胞形态学、免疫表型和细胞遗传学改变进行综合判断。病理诊断方面的特征主要包括:①经典型伯基特淋巴瘤细胞形态学表现为较均一、中等大小的肿瘤性B细胞弥漫性浸润增生;②表现为高增殖活性,ki67指数≥95%;③ 由于巨噬细胞吞噬凋亡细胞碎片产生的“星空现象”,这是BL病理诊断的一项特点。
BL病理表现
IHC 免疫表型方面,BL一般表达B细胞相关的抗原,包括CD19、CD20、CD22、CD79a以及BCL6和CD10等,亦可表达免疫球蛋白的IgM和单一的免疫球蛋白的轻链蛋白,不表达CD5、CD23、CD34、TDT及BCL2。
细胞遗传学方面,经典BL的特征是MYC基因重排(存在于8号染色体上)作为唯一的细胞遗传学异常,其中80%为t(8;14)(q24;q32),即c-Myc基因与IgH发生易位。另15%和5%分别为t(2; 8)和t(8; 22),即c-Myc基因和λ或κ轻链发生易位,导致MYC活化和细胞过度增殖。

BL的分型
既往WHO根据BL流行病学特征,将其分为地方型、散发型和免疫缺陷相关型。但考虑到EBV感染在BL早期发病机制中起到的重要作用,从2022年WHO发布的第5版造血与淋巴组织肿瘤分类(WHO-HAEM5)中便开始基于分子特征对BL进行分型,即分为EBV阳性Burkitt淋巴瘤和EBV阴性Burkitt淋巴瘤两大类。
BL的风险分层
基于已发表的成人伯基特淋巴瘤国际预后指数(BL-IPI)中所包含的4项独立不良预后因素(年龄 ≥ 40岁、ECOG ≥ 2分、LDH>3倍ULN和CNS受累),可将BL分为低风险组(无危险因素)、中风险组(1项危险因素)和高风险组(≥2项危险因素)。Adam J Olszewski教授等在2021年JCO期刊上发表的一项关于BL-IPI的研究中显示:①有≥2项危险因素的患者(高风险组)3年无进展生存率(PFS)仅为53%,而无危险因素(低风险组)患者3年PFS为92%;② 高风险组BL患者的3年总体生存(OS)为58%,而低风险组的3年OS可高达99%。


J. Clin. Oncol. 39,1129–1138
BL的预后及相关研究
BL侵袭性极高,对化疗较敏感,部分可治愈。儿童较成人预后好,年龄>40岁的患者预后差。复发时间3个月~5年不等,如5年内无复发,即可认为治愈。目前认为,影响BL预后的不良因素:骨髓及CNS受累、肿块直径>10cm,高LDH水平、达到CR的时间较长等。
在BL预后研究方面,近年来有多项研究表明TP53突变与BL不良预后存在相关性。2022年NATURE期刊上的一项研究对288例BL患者(191儿童 97成人)进行了靶向深度测序(包含134 个基因),结果显示TP53突变型BL患者的OS要低于TP53突变野生型患者,并且其累积的复发风险明显更高。而同样的结果在2023年BLOOD期刊上的另一项研究中也得到了证实。

Nature Communications, 2022 Feb

Blood, 2023 Feb
伯基特淋巴瘤(BL)治疗
治疗前评估及分期
BL治疗前应进行详细的评估,包括I级、II级及III级推荐,涵盖了常规检查、实验室检查、影像学检查、骨髓检查和分期等,具体内容见下表。
中国临床肿瘤学会(CSCO)淋巴瘤诊疗指南(2023年版)

BL的分期根据2014年Lugano改良分期标准,不再对淋巴瘤的大包块(bulky)病灶进行具体的数据限定,只需在病例中明确记载最大病灶之最大径即可;II期伴有大肿块的患者,应根据病理类型及疾病不良预后因素而酌情选择治疗原则,如伴有大包块的惰性淋巴瘤患者可选择局限期治疗模式,但是伴有大包块的侵袭性淋巴瘤患者,则应选择进展期治疗模式。
中国临床肿瘤学会(CSCO)淋巴瘤诊疗指南

BL治疗
治疗方面,成人BL采用常规的利妥昔单抗+CHOP方案(R-CHOP)疗效欠佳,目前常使用短期,多药物,剂量强化的化疗联合方案联合中枢神经系统治疗(儿童急性淋巴细胞白血病方案),获得了非常好的疗效,大部分患者可以长期生存,使得治愈成为可能。高危患者在完全缓解后可参加针对针对巩固治疗的临床试验。而放疗在Burkitt淋巴瘤中的作用有限。
《CSCO淋巴瘤诊疗指南》根据BL的危险分层给出了治疗方面的专家推荐。例如,对于低危BL患者,I级专家推荐包括剂量调整的 EPOCH方案(需甲氨蝶呤鞘内注射)+ 利妥昔单抗(2A类证据),CODOX-M+利妥昔单抗(2A类证据)、Hyper CVAD/MA方案+利妥昔单抗(2A类证据)。高危患者的I级专家推荐为剂量调整的 EPOCH方案(需甲氨蝶呤鞘内注射)+ 利妥昔单抗(2A类证据),CODOX-M与IVAC交替方案+利妥昔单抗(2A类证据)、Hyper CVAD/MA方案+利妥昔单抗(2A类证据)。具体详见下表。
中国临床肿瘤学会(CSCO)淋巴瘤诊疗指南

BL治疗的研究进展
1、目前最大型的BL真实世界研究(RWS)
Andrew M Evens教授等在2021年BLOOD期刊上发表了一项迄今为止最大型的BL真实世界研究(RWS),收集了从2009年~2018年间在美国30个癌症中心接受治疗的702例初诊BL成人患者。除去随访信息丢失等因素造成的数据缺失,最终纳入了641例BL患者, 通过数据的深入统计分析,旨在分析各治疗方案的对BL患者的疗效、生存影响和预后因素方面的差异。主要的研究终点指标包括无进展生存率(PFS)、总生存率(OS)、治疗相关死亡率(TRM)。结果显示:BL患者经治疗后的整体3年PFS为64%,OS为70%,见下图。

Andrew M Evens et al. Blood.2021 Jan 21;137(3):374-386
亚组分析:接受三种主流化疗方案(CODOX-M/IVAC、Hyper-CVAD/MA和DA-EPOCH-R)的患者PFS(P=0.220)和OS(P=0.390)无明显差异;接受利妥昔单抗治疗的患者生存率优于未接受的患者(3年PFS:67% vs. 38%,P<0.001; 3年OS:72% vs. 44%,P<0.001),见下图。

Andrew M Evens et al. Blood.2021 Jan 21;137(3):374-386
在学院型医院治疗的患者生存率优于在社区医院治疗的患者(3年PFS为67%vs. 46%,P=0.006;3年OS 72% vs. 53%,P=0.010)

Andrew M Evens et al. Blood.2021 Jan 21;137(3):374-386
安全性方面,总体治疗相关死亡率(TRM)为10%,常见死亡原因包括感染(31例,51%)、消化道出血/穿孔(9例,15%),以及呼吸衰竭(8例,15%)。不同治疗方案上,Hyper-CVAD/MA的TRM最高,达到11%,其次为DA-EPOCH(8%)、以及CODOX-M/IVAC(5%)。
在预后因素分析方面,单因素分析结果显示:年龄≥40岁、ECOG≥2分、晚期、骨髓受累、CNS受累、LDH>3×ULN、HB水平<11.5g/dL、ALB<3.5g/dL是与成人BL患者PFS相关的不良预后因素。多因素分析结果显示:年龄≥40岁、ECOG≥2分、 LDH>3×ULN、 CNS受累是BL的独立不良预后因素(BL IPI)。
2、NCI9177研究
2020年JCO期刊上报道了NCI9177研究的结果,得出以下结论:
DA-EPOCH-R对于低危/高危患者均安全有效,中位随访58.7个月,总体人群4年EFS 84.5% (95% CI: 76% ~ 90%), 4年OS 87.0% (95% CI: 79%~92%)。其中15名低危患者的4年EFS和OS 均为100%;98例高危患者的4年EFS 82.1% (95% CI: 73% ~89%), 4年OS 84.9% (95% CI: 76%~91%)。

JCO 2020 May
DA-EPOCH-R对于中枢受累的BL疗效欠佳,BL-IPI模式下,低危、中危、高危的5年 EFS分别为94.2%、83.6%、66.7%, 无论是低中危还是高危患者中,有CNS/BM受累的患者预后均劣于没有CNS/BM受累的患者。

JCO 2020 May
3、HOVON/SAKK研究
2023年,Lancet Hemato期刊发表了HOVON/SAKK研究的随访结果,入组了2014~2021年间89例高危、无中枢受累的BL患者,最终84例患者进入随机化分组(R-CODOX-M/R-IVAC组,n=43;DA-EPOCH-R组,n=41),中位随访时间19.1个月,旨在评估两组疗效及安全性。其结果显示,新诊断高危、无中枢受累的BL患者,DA-EPOCH-R与R-CODOX-M/R-IVAC疗效相当(详见下图),但前者风险更小。

Lancet Hemato 2023 Oct
4、CAR-T±ASCT治疗R/R-BL患者的相关研究进展
2022年Front Immunol期刊上发表了一项来自于中国的单中心研究,评价CD19/CD22 CAR -T单药(试验A)或者联合自体干细胞移植(ASCT, 试验B)在成人复发/难治伯基特淋巴瘤患者(R/R-BL)中的临床疗效和毒性,共入组了28例成R/R-BL患者[试验A(n=15)和试验B(n=13)]。其结果显示:①整体人群:19例(67.9%)达到客观缓解率(ORR),16例(57.1%) 完全缓解(CR);②中位随访12.5个月后,16例患者(试验A 5例,试验B 11例)存活,估计的1年PFS和OS均为55.6%。B组患者的1年PFS、OS明显优于A组;③与治疗后获得客观观缓解的相关的因素包括:TP53突变状态、基线LDH水平、是否有大包块、基线ECOG评分;④毒副反应:2/4级的CRS 39.3%, ICANS 10.7%。

Front Immunol. 2022;13:879983
小结
1. BL是高度侵袭性的NHL,多累及骨髓和CNS。c-MYC基因易位较为多见,80%为t(8;14)(q24;q32), Ki-67 95%以上。BL-IPI预后评估系统有助于对成人患者进行危险分层,TP53突变患者预后较差。
2. 治疗上,BL患者对化疗敏感,利妥昔单抗联合短疗程、大剂量化疗方案改善了预后。复发难治BL预后差,CAR-T等新药可能为这类患者带来新希望。

赵东陆 教授
哈尔滨血液病肿瘤研究所所长助理
血液科二病房(淋巴系统疾病)主任
中国临床肿瘤学会(CSCO)副秘书长
CSCO淋巴瘤专家委员会副秘书长
中华医学会血液学分会淋巴细胞疾病学会副组长
国家卫生健康委能力建设和继续教育肿瘤学专家委员会委员
中国抗癌协会血液肿瘤专业委员会委员
中国抗癌协会肿瘤血液病专业委员会委员
CSCO青年专家委员会委员
中国抗癌协会血液肿瘤专业委员会青年委员
中国老年医学会血液学分会恶性淋巴瘤学组委员
中国医药学会血液学分会淋巴瘤学组委员
黑龙江省医学会淋巴瘤分委会委员
黑龙江省医学会血液内科委员会委员
黑龙江省医师协会淋巴瘤骨髓瘤委会常委
黑龙江省医师协会血液内科专业委会委员